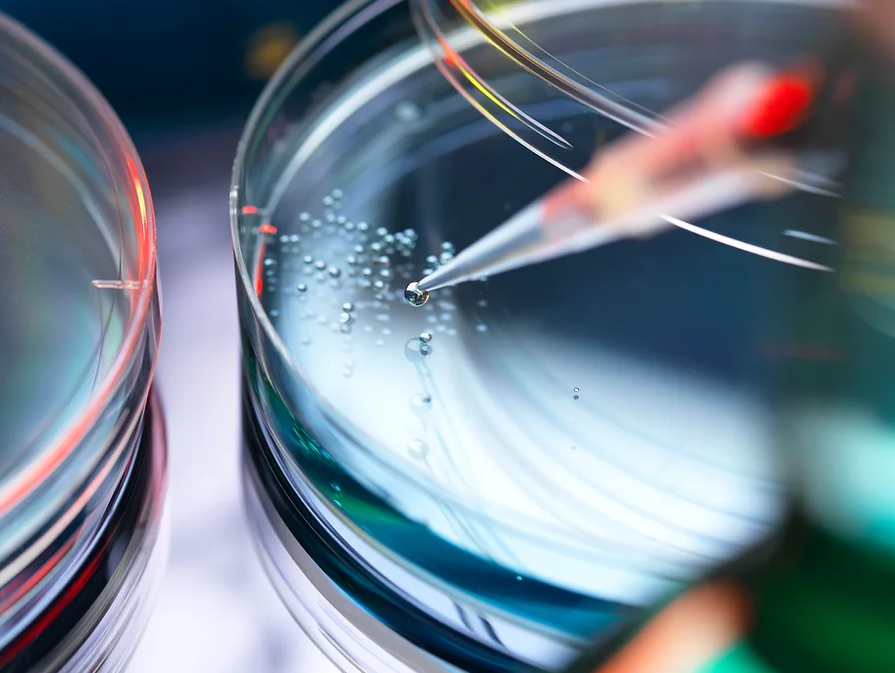

日本ヒト幹細胞医療美建協会について
Share

信用と信頼のシンボル
-認証ラベル-
分析・評価で、安心・安全をお届けします。
JSBAとは『ヒト幹細胞培養液配合化粧品の標準化』 を目的に行っております。 当協会にて、認定の基準値を設け、ヒト幹細胞培養液配合化粧品の測定結果がその基準を満たしている商品につきまして商品の認定しております。『ヒト幹細胞培養液が配合されていること』 を認定するものであり、効果や作用を保証するものではありません。
JSBA認証ラベルとは
JSBA認証ラベルは、推奨配合量が処方、配合された「ヒト幹細胞培養液配合商品」に与えられる、プレステージある認証です。高品質な製品であることをJSBAが推奨することで、消費者、ならびにメーカー様にとって様々な利点、正当性ある商品として販売頂ける美点です。
その他の一般化粧品成分、健康食品商品等に関しても、当協会が依頼する機関にて分析試験を行い、一定の基準値の配合が確認できる商品にも、認証シールを発行することが可能です。
認証マーク取得による利点・品質向上
本協議会の認証へ申請される企業様は、貴社商品の品質向上を認定推奨いたします。
認定条件
1.当協会の法人会員である。
2.協会にて分析し、ヒト幹細胞培養液がクラス1を超えている製品である。
・同一の製品であれば、過去の分析結
果も認定に適用されます。
・モデルチェンジは新製品となります。